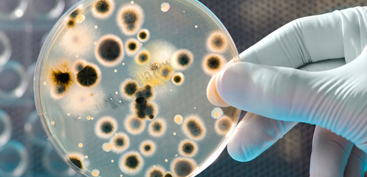

Mold Removal Gulf Shores, AL
It’s just a fact of life that, if there’s water present in a Home or Commercial property, it can quickly become infested with mold. In as little as 48 hours mold can spread throughout a property. Mold is known to produce allergens and irritants and in the concerns of safety for your family, you should have your Baldwin County Home tested as soon as possible if you suspect mold being present. If mold is found Modern Environmental Service and Sales has the training, the experience and the expertise required to remediate your mold infestation.
If You See Signs of Mold, Call Us Today – 251.981.3032
Understanding Mold
It’s an outright lie that anyone, including us can completely remove all the mold from a home or business. Very commonly companies will guarantee the ability to do so and this is misleading. Microscopic mold spores exist almost everywhere, both indoors and outdoors. Here are the facts:
- Mold is present almost everywhere, indoors and outdoors.
-
- Mold spores are microscopic and float along in the air and may enter your home through windows, doors, or AC/heating systems or even hitch a ride indoors on your clothing or a pet.
-
- Mold spores thrive on moisture. Mold spores can quickly grow into colonies when exposed to water. These colonies may produce allergens and irritants.
-
- Before mold remediation can begin, any sources of water or moisture must be addressed. Otherwise, the mold may return.
-
- Mold often produces a strong, musty odor and can lead you to possible mold problem areas.
-
- Even higher-than-normal indoor humidity can support mold growth. Keep indoor humidity below 45 percent.
-
We provide mold removal and remediation in Baldwin and Mobile Counties 24/7 for your convenience. Our technicians are trained and experienced to handle all types of mold cases. Our goal is to treat the mold problem and help you bring your life back to normal as soon as possible. We also provide mold testing, mold removal and evaluations for remediation and removal.
Mold Testing Gulf Shores, AL
If you suspect you have mold we will perform a lab test which will include a surface mold analysis along with an air quality test. These tests will identify the level of toxicity along with the type of mold located at your property. Mold testing is recommended once the inspection has been completed and results have turned out positive.
Black Mold & Toxic Mold Removal in Gulf Shores, AL

Toxic Black Mold Symptoms
Black mold is a slimy greenish-black mold that is extremely toxic to inhale and can even cause extreme irritation to the skin if physically touched. This mold should be treated immediately as it will spore and spread through the surface area and can severely affect ones health. Black mold will hurt your immune system if not treated accordingly.
Other Areas We Serve:
Mold Removal in Fairhope, AL| Mold Removal in Foley, AL | Mold Removal in Gulf Shores, AL | Mold Removal in Mobile, AL